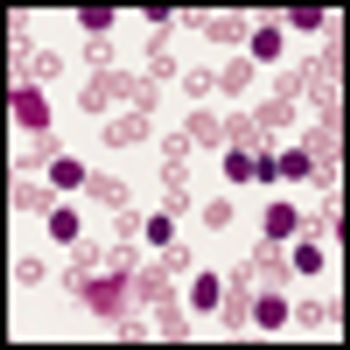

A new study shows that men diagnosed with prostate cancer may do better by substituting carbohydrates and saturated fats with plant-based fats such as those found in nuts and olive oil.

A new study shows that men diagnosed with prostate cancer may do better by substituting carbohydrates and saturated fats with plant-based fats such as those found in nuts and olive oil.

The Supreme Court announced a unanimous 9-0 decision that genes cannot be patented. After a long legal battle, the high court ruled against Myriad’s patents on two breast cancer susceptibility genes-BRCA1 and BRCA2-declaring that genes are products of nature and cannot be treated as inventions.

A single-center study analyzed the frequency of breast cancer susceptibility mutations among black women diagnosed with breast cancer. The findings suggest that broader genetic screening may be beneficial for these women. The study also suggests that family history is not the only criteria by which patients at risk for breast cancer can be identified.

In a study presented at ASCO, a team of researchers used microarrays to characterize 130 triple-negative breast cancer patients treated with neoadjuvant chemotherapy to see whether certain subtypes are more likely to respond to the treatment.

A study presented at ASCO shows that axillary radiotherapy results in similar outcomes to axillary lymph node dissection, but halved the incidence of lymphedema.

A phase III trial presented at ASCO showed similar efficacy between two adjuvant paclitaxel regimens, but the weekly regimen led to fewer patient side effects.

Women diagnosed with estrogen-receptor (ER)-positive breast cancer who took tamoxifen for 10 years as adjuvant therapy had lower risk of late recurrence and lower risk of death compared to those who took the drug for 5 years. These results corroborate the findings of the international ATLAS trial.

Survival data of prostate cancer patients 70 and older show that those with three or more comorbidities and low- or intermediate-risk prostate cancer are less likely to die from prostate cancer than another health issue. But those with aggressive, high-risk disease are more likely to die from their prostate cancer.

A new population-based study of never-smokers shows those with gastric reflux are more likely to be diagnosed with cancers of the throat, including the voice box.

A large study shows that middle-age men engaged in lots of cardiovascular exercise have a reduced risk of developing and dying from lung and colorectal cancer.

The FDA approved a label expansion for erlotinib (Tarceva), along with the cobas EGFR mutation diagnostic test, to include patients untreated metastatic NSCLC patients whose tumors have either a deletion in exon 19 or exon 21 (L858R) substitution mutations in the EGFR gene.

Two genome-wide studies have identified a total of 12 new genetic loci associated with a higher risk of testicular cancer. The risk-associated genetic variations could help clinicians single out higher-risk men for screening and early detection.

A cohort-based study found that men with prostate cancer who took cholesterol-lowering statins had a lower risk of dying from their prostate cancer.

In the HERA trial, benefit for invasive lobular breast cancer patients with 1 year of trastuzumab maintenance was similar to invasive ductal carcinoma patients.

Researchers have characterized acute myeloid leukemia, providing new genetic driver leads to help classify the disease and even stratify AML patients by risk.

The FDA’s Oncologic Drugs Advisory Committee has voted 13 to 1 against AVEO's drug tivozanib for the treatment of patients with metastatic renal cell carcinoma.

Four of the nation’s cancer organizations--including the COA and ASCO--believe that the sequestration cuts will impact the treatment of cancer patients on Medicare and have sent letters to Congress and the Department of Health and Human Services.

A case-control study of almost 500 men suggests that obese men who have had a benign prostate biopsy have a greater risk of prostate cancer in the future.

The US Preventive Services Task Force, an influential panel of experts, said that women at high risk for breast cancer should consider taking breast cancer drugs to decrease their risk.

Researchers have identified the enzyme PKCζ, which acts as a tumor suppressor in prostate cancer and is part of a pathway that partly controls cell growth and metastasis.

Patients with stage III colon cancer who have a history of smoking are more likely to have worse outcomes, according to a large, randomized phase III trial result.

The anti-PD-L1 antibody MPDL3280A is effective for several different cancers and was well tolerated. Responses were seen in lung, kidney, colon, and stomach cancer patients. All patients who responded are continuing to respond to the treatment.

A new agent, SAR245409, that simultaneous targets two pathways important for the growth of tumors--the PI3K/mTOR pathway and the MAPK pathway--has shown activity in advanced solid tumors, according to results from a phase I trial presented at the American Association for Cancer Research Annual Meeting.

A novel therapy has shown activity in the treatment of difficult-to-treat, advanced, platinum-resistant ovarian cancer. The drug, DMUC5754A, is part of a new class of drugs called antibody-drug conjugates.

Washington, DC-“Triple-negative breast tumors are composed of mosaic cancer cells with distinct genetic aberrations,” said Jorge S. Reis-Filho, MD, PhD, a surgical pathologist at the Memorial Sloan-Kettering Cancer Center in New York, who combines traditional pathology, gene expression profiling, and genomics techniques to understand rare breast tumor types, including triple-negative diseases.

Researchers participating in the phase III EMILIA trial have identified tumor biomarkers that can identify patients that are more likely to benefit from T-DM1. In the trial, women whose tumors had higher HER2 expression were most likely to benefit from the therapy.
Researchers have identified a novel monoclonal antibody directly targeted against a receptor found in abundance on chronic lymphocytic leukemia (CLL) cells, but not normal B cells. The humanized antibody can directly kill CLL cells.

Researchers have identified a mechanism by which prostate cancer resists hormonal therapy to develop into castration-resistant prostate cancer (CRPC). The protein SIAH2 keeps a fraction of androgen receptors constitutively active in prostate cancer cells.

Using blood samples of pancreatic cancer and chronic pancreatitis patients, researchers in Japan have developed a metabolomics-based test that may be an easy and noninvasive way to detect pancreatic cancer.

Imaging is important for both the diagnosis and management of prostate cancer. Standard techniques used in everyday clinical practice depend on the stage of the disease. Several new experimental modalities are currently in development to better identify and diagnose patients with progressive disease.